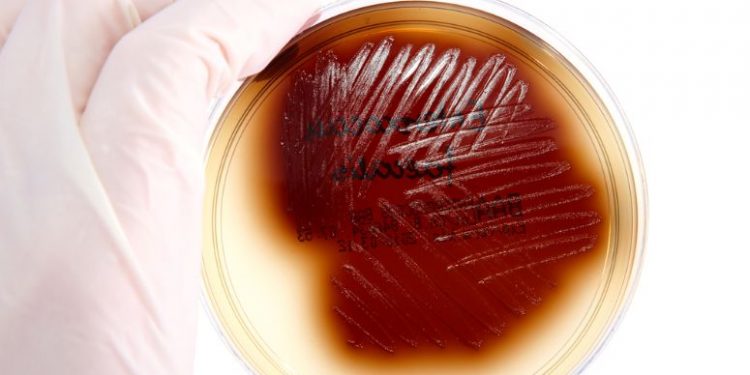
Asymptomatic Bacterial Urinary Tract Infection

Asymptomatic bacteriuria is one of the most common types of urinary tract infection. Asymptomatic bacteriuria is usually diagnosed when a urine culture shows bacteria. In general, women are more likely to develop asymptomatic bacteriuria than men. However, this condition can affect people of any gender. For example, pregnant women are more likely to develop asymptomatic urinary sepsis than non-pregnant women.
Although the most common infectious agent is group B streptococcus, other organisms can also infect the urinary tract. The most common organisms are Escherichia coli and Enterococcus species. When the urinary tract is infected, symptoms include a fever, pain, and diarrhoea. Bacteria can infect the kidneys and cause pyelonephritis. Symptoms can vary from mild to severe. If you develop a urinary tract infection, contact your doctor immediately. You may require antibiotics and hospitalization to treat the infection.
Several factors can increase the risk of developing asymptomatic bacteriuria. This includes preexisting urinary tract abnormalities, sexual intercourse, and pregnancy. Women with asymptomatic bacteriuria are also at increased risk for pyelonephritis during pregnancy. Moreover, the presence of asymptomatic bacteriuria increases the risk for premature delivery and other complications of pregnancy. It is important to have regular urine testing.
While many patients with asymptomatic bacteriuria do not require treatment, some do. These patients are often catheter users and have a higher rate of recurrent UTI. Antibiotic treatment has been shown to decrease the risk of pyelonephritis. Studies have also shown that treating asymptomatic bacteriuria has a positive impact on fetal outcomes.
Pregnant women should be screened for asymptomatic bacteriuria during the first trimester. During this time, asymptomatic bacteriuria can increase the risk of pyelonephritis by more than thirty-fold. Treatment is not indicated for pregnant women who are not at high risk of pyelonephritis.
Asymptomatic bacteriuria is most common in women, and the majority of people with this condition are not treated. Despite this, treatment has shown improvements in patient outcomes. Research has also shown that women with asymptomatic bacteriuria have a high risk of developing antibiotic-resistant urinary tract infections.
One of the best ways to avoid asymptomatic bacteriuria is to wash your hands and avoid wearing perfumes. It is also a good idea to shower frequently. Personal hygiene is important for all ages. Contact your doctor or midwife for advice.
Other factors that can contribute to the development of asymptomatic bacteriuria include pregnancy and urinary incontinence. Women who have a history of urinary tract infection or pyelonephritis should be screened for asymptomatic bacteria. They should also be evaluated for reflux nephropathy and reflux pyelonephritis.
Although antibiotic treatment is not recommended for asymptomatic bacteriuria, it has improved the patient outcome. Treatment has also been linked with a higher risk of future problems with antibiotic use. Moreover, treating asymptomatic bacteriuria does not prevent the development of future complicated urinary tract infections. As a result, antibiotic prophylaxis is not recommended for most patients with risk factors for complicated UTI.
Women who have diabetes should be screened for asymptomatic urinary bacteriuria. A study showed that the number of infected women was greater than the number of uninfected women. However, the rates of mortality and diabetic complications were not increased.